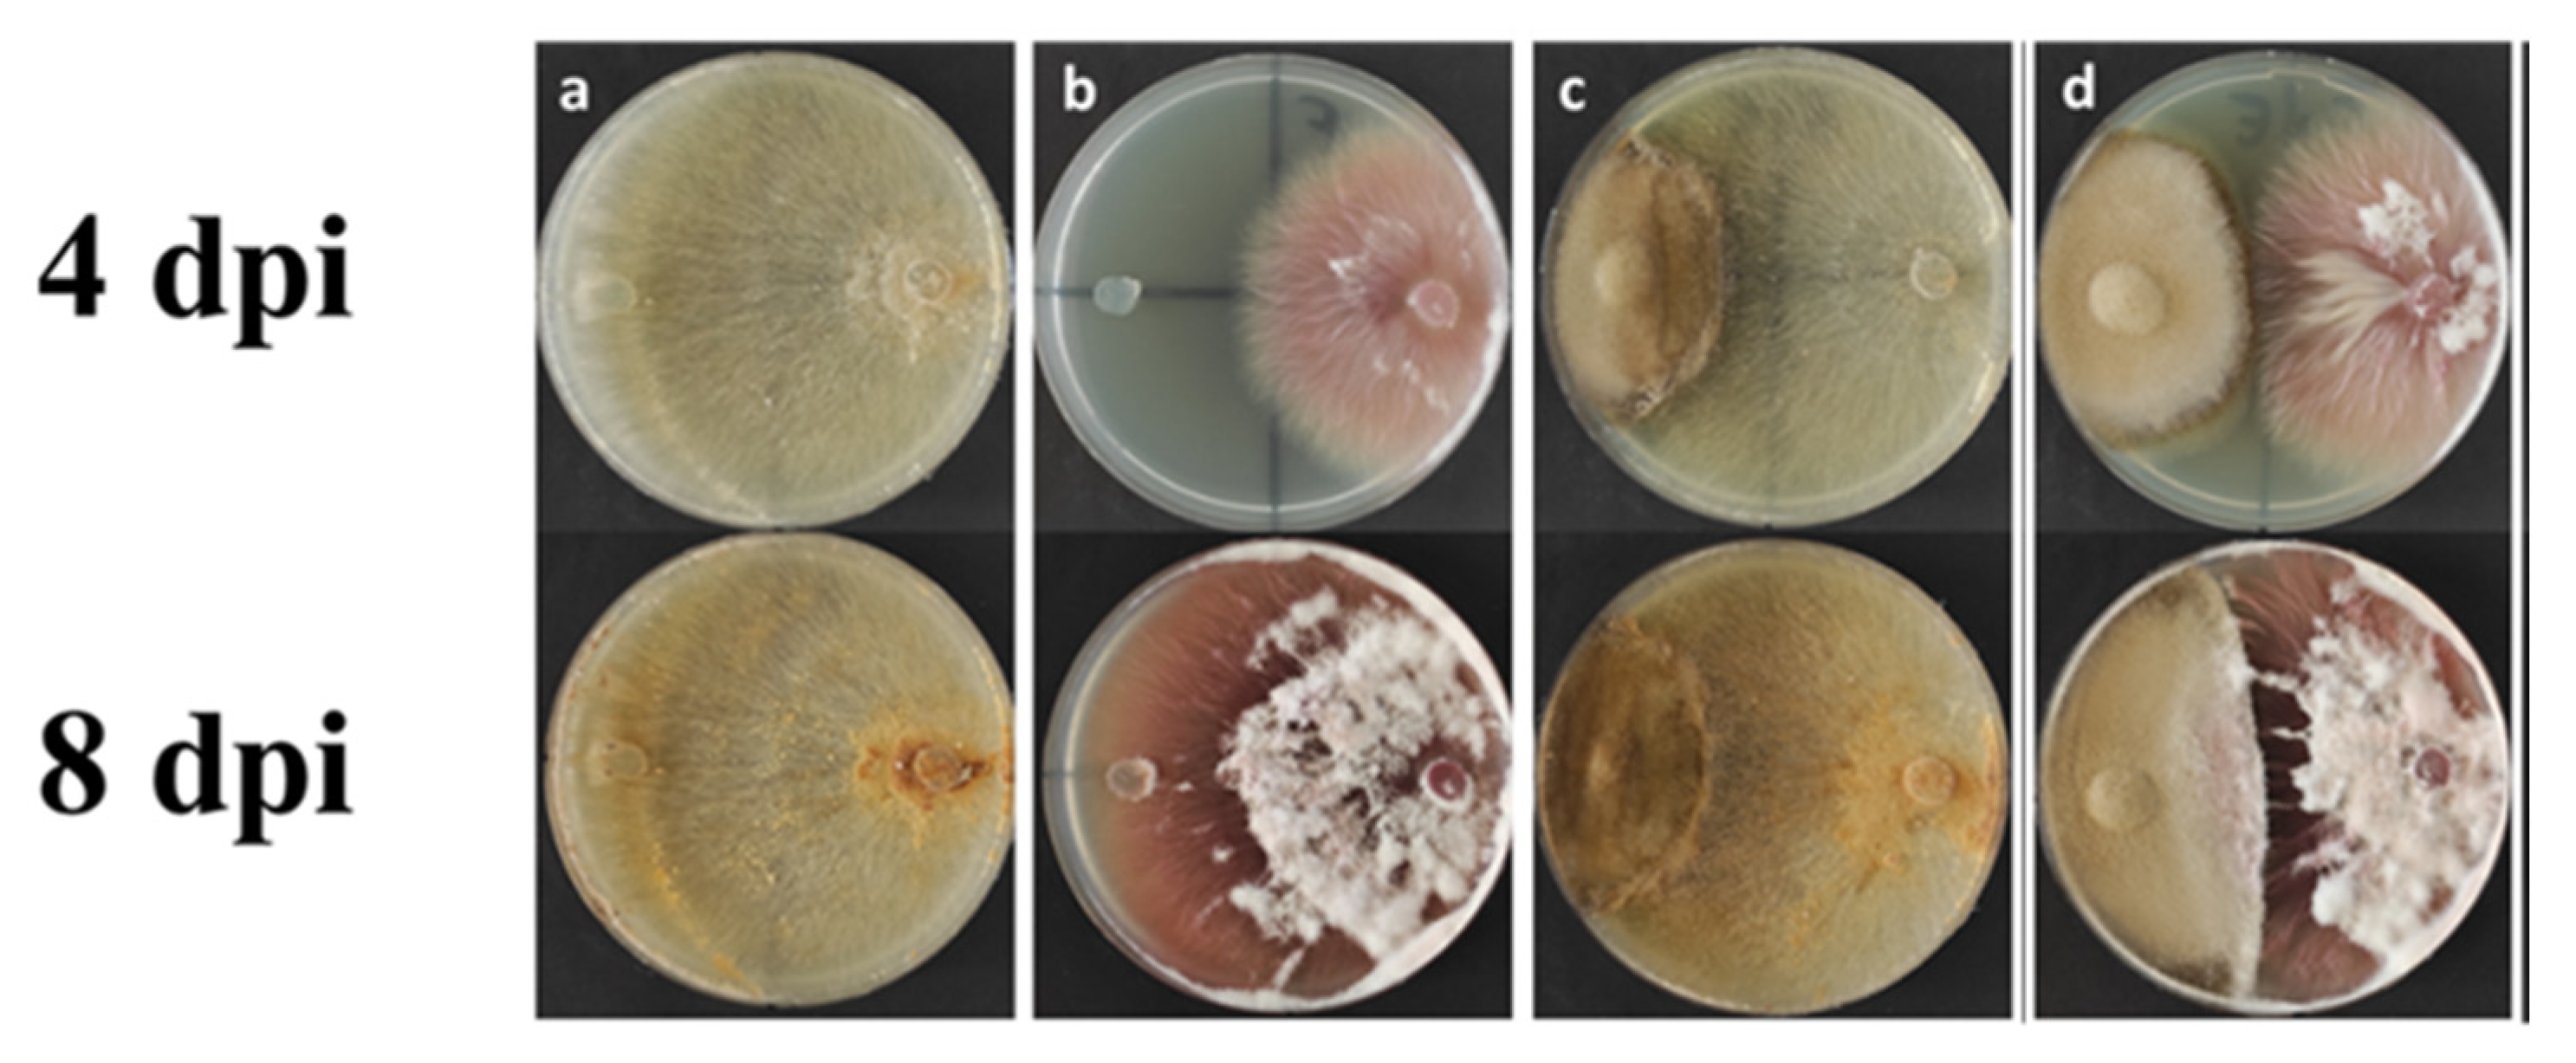
Plants 11 00924 g007 Plants 11 00924 g007

Mycorrhized Wheat Plants and Nitrogen Assimilation in Coexistence and Antagonism with Spontaneous Colonization of Pathogenic and Saprophytic Fungi in a Soil of Low Fertility
Abstract
1. Introduction
2. Results
2.1. Mycorrhization of Roots and Durum Wheat Development
2.2. Nitrogen Metabolism
2.3. Free Amino Acids Content in NM and M Plants
2.4. Isolation and Identification of Endophytic Fungi from Plant Roots in the Field
2.5. Cellulase Test on the Endophytic Fungi from Plant Roots
2.6. Root Microscopy
2.7. Evaluation of Fungal Competition via Dual Culture Assay of Alternaria tellustris
3. Discussion
3.1. Root Mycorrhization and Plant Growth
3.2. Nitrogen Assimilation
3.3. Variation of Free Amino Acid Level and Distribution in Roots and Leaves of Mycorrhized Durum Wheat Plants
3.4. Fungal Screening in Roots of Wheat Plants and Possible Antagonism between Mycorrhizal Fungi and Pathogenic Endophytes
3.5. Spontaneous Colonization of Soil DSE, an Ecological Niche between Saprophytic Microorganisms and Pathogens of the Root System
4. Materials and Methods
4.1. Mycorrhizal Spore Inoculum for Seeds
4.2. Physical and Chemical Analysis of the Soil Samples
4.3. Fertilization Plan
- (1)
- Basic fertilization: 100 kg per hectare (kg ha−1)Fertilizer composition: 6% total nitrogen (1% organic N; 2% NO3−-N; 3% ureic N);18% total phosphoric anhydride (P2O5); 32% water-soluble P2O5; 20% total CaO; 15% water-soluble sulfur anhydride (SO3); 7.5% organic carbon of biological origin.
- (2)
- Phenological phase of the beginning of tillering: nitrogen fertilizer 180 kg ha−1 (NM) parcel 1 and 90 kg ha−1 (M) parcel 2.Composition: 30% ureic N; 30% NO3−-N; 15% water-soluble SO3. Fertilization was repeated after a week.
- (3)
- Phenological phase of the beginning of stem elongation: nitrogen fertilizer 200 kg ha−1 (NM) parcel 100 ha−1 (M) parcel 2. Composition: 30% ureic N; 30% NO3−-N; 20% water-soluble SO3. Fertilization was repeated after a week.
4.4. Sampling, Plant Growth and Mycorrhizal Colonization Analyses
4.5. Primary Amino Acid Analyses
4.6. Nitrate Reductase Assimilatory and Glutamine Synthetase Activity Assays
4.7. Root Microscopy
4.8. Isolation of Endophytic Fungi
4.9. Molecular Identification of Fungi
4.10. Evaluation of Fungal Competition by Dual Culture Assay of Alternaria tellustris
4.11. Statistical Analysis
5. Conclusions
Author Contributions
Funding
Institutional Review Board Statement
Informed Consent Statement
Data Availability Statement
Conflicts of Interest
References
- Wang, B.; Qiu, Y.L. Phylogenetic distribution and evolution of mycorrhizas in land plants. Mycorrhiza 2006, 16, 299–363. [Google Scholar] [CrossRef]
- Di Martino, C.; Crawford, T.W., Jr. Roles and implications of arbuscular mycorrhizas in plant nutrition. In Handbook of Plant and Crop Physiology, 4th ed.; CRC Press: Boca Raton, FL, USA, 2021; Chapter 18; pp. 321–341. ISBN 978-036-755-454-5. [Google Scholar]
- Van der Heijden, M.G.A.; Sanders, I.R. Mycorrhizal Ecology Ecological Studies; Springer: Berlin/Heidelberg, Germany, 2003. [Google Scholar]
- Smith, S.E.; Read, D.J. Mycorrhizal Symbiosis, 3rd ed.; Academic Press: London, UK, 2008. [Google Scholar]
- Di Martino, C.; Palumbo, G.; Vitullo, D.; Di Santo, P.; Fuggi, A. Regulation of mycorrhiza development in durum wheat by P fertilization: Effect on plant nitrogen metabolism. J. Plant Nutr. Soil Sci. 2018, 181, 429–440. [Google Scholar] [CrossRef]
- Nouri, E.; Breuillin-Sessoms, F.; Feller, U.; Reinhardt, D. Phosphorus and nitrogen regulate arbuscular mycorrhizal symbiosis in Petunia hybrida. PLoS ONE 2014, 9, e90481. [Google Scholar] [CrossRef]
- Kaldorf, M.; Zimmer, W.; Bothe, H. Genetic evidence for the occurrence of assimilatory nitrate reductase in arbuscular-mycorrhizal and other fungi. Mycorrhiza 1994, 5, 23–28. [Google Scholar] [CrossRef]
- Kaldorf, M.; Schmelzer, E.; Bothe, H. Expression of maize and fungal nitrate reductase genes in arbuscular mycorrhiza. Mol. Plant Microbe Int. 1998, 11, 439–448. [Google Scholar] [CrossRef] [PubMed]
- Johansen, A.; Finlay, R.D.; Olsson, P.A. Nitrogen metabolism of external hyphae of the arbuscular mycorrhizal fungus Glomus intraradices. New Phytol. 1996, 133, 705–712. [Google Scholar] [CrossRef]
- Govindarajulu, M.; Pfeffer, P.E.; Jin, H.; Abubaker, J.; Douds, D.D.; Allen, J.W.; Bücking, H.; Lammers, P.J.; Shachar-Hill, Y. Nitrogen transfer in the arbuscular-mycorrhizal symbiosis. Nature 2005, 435, 819–823. [Google Scholar] [CrossRef] [PubMed]
- Tian, C.; Kasiborski, B.; Koul, R.; Lammers, P.J.; Bücking, H.; Shachar-Hill, Y. Regulation of the nitrogen transfer pathway in the arbuscular mycorrhizal symbiosis: Gene characterization and the coordination of expression with nitrogen flux. Plant Physiol. 2010, 153, 1175–1187. [Google Scholar] [CrossRef]
- Zeilinger, S.; Gupta, V.K.; Tanya, E.S.; Dahms, T.E.S.; Silva, R.N.; Singh, H.B.; Upadhyay, R.S.; Gomes, E.V.; Clement Kin-Ming Tsui, C.K.M.; Nayak, C. Friends or foes? Emerging insights from fungal interactions with plants. FEMS Microbiol. Rev. 2016, 45, 182–207. [Google Scholar] [CrossRef]
- Yang, H.; Dai, Y.; Wang, X.; Zhang, Q.; Zhu, L.; Bian, X. Meta-Analysis of Interactions between Arbuscular Mycorrhizal Fungi and Biotic Stressors of Plants. Sci. World J. 2014, 2014, 746506. [Google Scholar] [CrossRef]
- Liu, H.; Wu, M.; Liu, J.; Qu, Y.; Gao, Y.; Ren, A. Tripartite Interactions Between Endophytic Fungi, Arbuscular Mycorrhizal Fungi, and Leymus chinensis. Microb. Ecol. 2020, 79, 98–109. [Google Scholar] [CrossRef]
- Jumpponen, A.; Trappe, J.M. Dark septate endophytes: A review of facultative biotrophic root-colonizing fungi. New Phytol. 1998, 140, 295–310. [Google Scholar] [CrossRef]
- Mandyam, K.; Jumpponen, A. Seeking the elusive function of the root-colonising dark septate endophytic fungi. Stud. Mycol. 2005, 53, 173–189. [Google Scholar] [CrossRef]
- Lugtenberg, B.J.J.; Caradus, J.R.; Johnson, L.J. Fungal endophytes for sustainable crop production. FEMS Microbiol. Ecol. 2016, 92, fiw194. [Google Scholar] [CrossRef]
- Lukešová, T.; Kohout, P.; Větrovský, T.; Vohník, M. The Potential of Dark Septate Endophytes to Form Root Symbioses with Ectomycorrhizal and Ericoid Mycorrhizal Middle European Forest Plants. PLoS ONE 2005, 10, e0124752. [Google Scholar] [CrossRef]
- Varma, A.; Verma, S.; Sudha; Sahay, N.; Butehorn, B.; Franken, P. Piriformospora indica, a cultivable plant-growth-promoting root endophyte. Appl. Environ. Microbiol. 1999, 65, 2741–2744. [Google Scholar] [CrossRef]
- Kumari, R.; Kishan, H.; Bhoon, Y.K.; Varma, A. Colonization of cruciferous plants by Piriformospora indica. Curr. Sci. 2003, 85, 1672–1674. [Google Scholar]
- Bücking, H.; Kafle, A. Role of arbuscular mycorrhizal fungi in the nitrogen uptake of plants: Current knowledge and research gaps. Agronomy 2015, 5, 587–612. [Google Scholar] [CrossRef]
- Sherameti, I.; Shahollari, B.; Venus, Y.; Aaltshmied, L.; Varma, A.; Oelmüller, R. The endophytic fungus Piriformospora indica stimulates the expression of nitrate reductase and the starch-degrading enzyme glucan-water dikinase in tobacco and Arabidopsis roots through a homeodomain transcription factor that binds to a conserved motif in their promoters. J. Biol. Chem. 2005, 280, 26241–26247. [Google Scholar] [CrossRef]
- Cruz, C.; Fegghi, Z.; Martins-Loução, M.A.; Varma, A. Plant Nitrogen Use Efficiency May be Improved through Symbiosis with Piriformospora indica. In Piriformospora indica: Sebacinales and Their Biotechnological Applications; Soil Biology, Varma, A., Kost, G., Oelmüller, R., Eds.; Springer: Berlin, Heidelberg, 2013; Volume 33, pp. 285–293. [Google Scholar] [CrossRef]
- Reininger, V.; Sieber, T.N. Mitigation of antagonistic effects on plant growth due to root co-colonization by dark septate endophytes and ectomycorrhiza. Environ. Microbiol. Rep. 2013, 5, 892–898. [Google Scholar] [CrossRef]
- Sawers, R.J.H.; Gutjahr, C.; Paszkowski, U. Cereal mycorrhiza: An ancient symbiosis in modern agriculture. Trends Plant Sci. 2008, 13, 96. [Google Scholar] [CrossRef] [PubMed]
- Usuki, F.; Narisawa, K. A mutualistic symbiosis between a dark septate endophytic fungus, Heteroconium chaetospira, and a nonmycorrhizal plant, Chinese cabbage. Mycologia 2007, 99, 175–184. [Google Scholar] [CrossRef] [PubMed]
- Jumpponen, A. Dark septate endophytes—Are they mycorrhizal? Mycorrhiza 2001, 11, 207–211. [Google Scholar] [CrossRef]
- Chatterjee, S.; Ghosh, R.; Mandal, N.C. Production of bioactive compounds with bactericidal and antioxidant potential by endophytic fungus Alternaria alternata AE1 isolated from Azadirachta indica A. Juss. PLoS ONE 2019, 14, e0214744. [Google Scholar] [CrossRef]
- Nicholson, P.; Chandler, E.; Draeger, R.C.; Gosman, N.E.; Simpson, D.R.; Thomsett, M.; Wilson, A.H. Molecular tools to study epidemiology and toxicology of Fusarium head blight of cereals. Eur. J. Plant Pathol. 2003, 109, 691–703. [Google Scholar] [CrossRef]
- Somma, S.; Petruzzella, A.L.; Logrieco, A.F.; Meca, G.; Cacciola, O.S.; Moretti, A. Phylogenetic analyses of Fusarium graminearum strains from cereals in Italy, and characterisation of their molecular and chemical chemotypes. Crop Pasture Sci. 2014, 65, 52–60. [Google Scholar] [CrossRef]
- Xu, X.-M.; Nicholson, P.; Thomsett, M.A.; Simpson, D.; Cooke, B.M.; Doohan, F.M.; Brennan, J.; Monaghan, S.; Moretti, A.; Mule, G.; et al. Relationship between the fungal complex causing Fusarium head blight of wheat and environmental conditions. Phytopathology 2008, 98, 69–78. [Google Scholar] [CrossRef]
- Kosiak, B.; Torp, M.; Skjerve, E.; and Thrane, U. The prevalence and distribution of Fusarium species in Norwegian cereals: A survey. Acta Agric. Scand. Sect. B Soil Plant Sci. 2003, 53, 168–176. [Google Scholar] [CrossRef]
- Logrieco, A.; Bottalico, A.; Mulé, G.; Moretti, A.; Perrone, G. Epidemiology of toxigenic fungi and their associated mycotoxins for some Mediterranean crops. Eur. J. Plant Pathol. 2003, 109, 645–667. [Google Scholar] [CrossRef]
- Xu, X.-M.; Parry, D.W.; Nicholson, P.; Thomsett, M.A.; Simpson, D.; Edwards, S.G.; Cooke, B.M.; Doohan, F.M.; Brennan, J.M.; Moretti, A.; et al. Predominance and association of pathogenic fungi causing Fusarium ear blight in wheat in four European countries. Eur. J. Plant Pathol. 2005, 112, 143–154. [Google Scholar] [CrossRef]
- USDA, Agricultural Research Service. National Plant Germplasm System; Germplasm Resources Information Network (GRIN Taxonomy); National Germplasm Resources Laboratory: Beltsville, MD, USA, 2022. [Google Scholar]
- Mojid, M.A.; Wyseure, G.C.L.; Biswas, S.K. Requirement of nitrogen, phosphorus and potassium fertilizers for wheat cultivation under irrigation by municipal wastewater. J. Soil Sci. Plant Nutr. 2012, 12, 655–665. [Google Scholar] [CrossRef][Green Version]
- Baum, C.; Makeschin, F. Effects of nitrogen and phosphorous fertilization on mycorrhizal formation of two poplar clones (Populus trichocarpa and P. tremula × P. tremuloides). J. Plant Nutr. Soil Sci. 2000, 163, 491–497. [Google Scholar] [CrossRef]
- Grant, C.; Bittman, S.; Montreal, M.; Plenchette, C.; Morel, C. Soil and fertilizer phosphorus: Effects on plant P supply and mycorrhizal development. Can. J. Plant Sci. 2005, 85, 1. [Google Scholar] [CrossRef]
- Tanaka, Y.; Yano, K. Nitrogen delivery to maize via mycorrhizal hyphae depends on the form of N supplied. Plant Cell Environ. 2005, 28, 1247–1254. [Google Scholar] [CrossRef]
- Németh, E.; Nagy, Z.; Pécsváradi, A. Chloroplast glutamine synthetase, the key regulator of nitrogen metabolism in wheat, performs its role by fine regulation of enzyme activity via negative cooperativity of its subunits Front. Plant Sci. 2018, 9, 191. [Google Scholar] [CrossRef]
- Breuninger, M.; Trujillo, C.G.; Serrano, E.; Fischer, R.; Requena, N. Different nitrogen source modulate activity but not expression of glutamine synthetase in arbuscular fungi. Fungal Genet. Biol. 2004, 41, 542–552. [Google Scholar] [CrossRef]
- Millard, R.; Wendler, R.; Hepburn, A.; Smith, A. Variations in the amino acid composition of xylem sap of Betula pendula Roth. trees due to remobilization of stored N in the spring P. Plant Cell Environ. 1998, 21, 715–722. [Google Scholar] [CrossRef]
- Cruz, C.; Egsgaard, H.; Trujillo, C.; Ambus, P.; Requena, N.; Martins-Loução, M.A.; Jakobsen, I. Enzymatic evidence for the key role of arginine in nitrogen translocation by arbuscular mycorrhizal fungi. Plant Physiol. 2007, 144, 782–792. [Google Scholar] [CrossRef]
- Summers, J.E.; Ratcliffe, R.G.; Jackson, M.B. Anoxia tolerance in the aquatic monocot Potamogeton pectinatus: Absence of oxygen stimulates elongation in association with an unusually large Pasteur effect. J. Exp. Bot. 2000, 51, 1413–1422. [Google Scholar]
- Lohse, S.; Schliemann, W.; Ammer, C.; Kopka, J.; Strack, D.; Fester, T. Organization and metabolism of plastids and mitochondria in arbuscular mycorrhizal roots of Medicago truncatula. Plant Physiol. 2005, 139, 329–340. [Google Scholar] [CrossRef][Green Version]
- Hughes, J.K.; Hodge, A.; Fitter, A.H.; Atkin, O.K. Mycorrhizal respiration: Implications for global scaling relationships. Trends Plant Sci. 2008, 13, 583–588. [Google Scholar] [CrossRef] [PubMed]
- Hughes, A.R.; Inouye, B.D.; Johnson, M.T.J.; Underwood, N.; Vellend, M. Ecological consequences of genetic diversity. Ecol. Lett. 2008, 11, 609–623. [Google Scholar] [CrossRef] [PubMed]
- Saikkonen, K.; Faeth, S.H.; Helander, M.; Sullivan, T.J. Fungal endophytes: A continuum of interactions with host plants. Annu. Rev. Ecol. Syst. 1998, 29, 319–343. [Google Scholar] [CrossRef]
- Schulz, B.; Rommert, A.K.; Dammann, U.; Aust, H.J.; Strack, D. The endophyte-host interaction: A balanced antagonism? Mycol. Res. 1999, 103, 1275–1283. [Google Scholar] [CrossRef]
- Schulz, B.; Boyle, C. The endophytic continuum. Mycol. Res. 2005, 109, 661–686. [Google Scholar] [CrossRef]
- Yeh, C.M.; Chung, K.M. between Orchids and Fungi. Appl. Sci. 2019, 9, 585. [Google Scholar] [CrossRef]
- Hashad, N.; Ibrahim, R.; Mady, M.; Abdel-Aziz, M.S.; Moharram, F.A. Bioactive metabolites and host-specific toxins from endophytic fungi, Alternaria alternate. Vietnam J. Chem. 2021, 59, 732–759. [Google Scholar] [CrossRef]
- de Sain, M.; Rep, M. The Role of pathogen-secreted proteins in fungal vascular wilt diseases. Int. J. Mol. Sci. 2015, 16, 23970–23993. [Google Scholar] [CrossRef]
- Schleusner, Y.; Bandte, M.; Gossmann, M.; Heiermann, M.; Plöchl, M.; Büttner, C. Survival of Alternaria alternata during anaerobic digestion of biomass in stirred tank reactors Commun. Agric. Appl. Biol. Sci. 2012, 77, 79–84. [Google Scholar]
- Harsonowati, W.; Surono, M.M.; Narisawa, K. The Effectiveness of a dark septate endophytic fungus, Cladophialophora chaetospira SK51, to mitigate Strawberry Fusarium Wilt Disease and with growth promotion activities. Front Microbiol. 2020, 11, 585. [Google Scholar] [CrossRef]
- Santos, M.; Cesanelli, I.; Diánez, F.; Sánchez-Montesinos, B.; Moreno-Gavíra, A. Advances in the role of dark septate endophytes in the plant resistance to abiotic and biotic stresses. J. Fungi 2021, 7, 939. [Google Scholar] [CrossRef] [PubMed]
- Lahlali, R.; Linda McGregor, L.; Song, T.; Gossen, B.D.; Narisawa, K.; Peng, G. Heteroconium chaetospira induces resistance to clubroot via upregulation of host genes Involved in jasmonic acid, ethylene, and auxin biosynthesis. PLoS ONE 2014, 9, e94144. [Google Scholar] [CrossRef] [PubMed]
- MiPAF. Ministero delle Politiche Agricole e Forestali. In Metodi di Analisi Chimica del Suolo; Violante, P., Ed.; Franco Angeli Editore: Roma, Italy, 1999. [Google Scholar]
- Giovannetti, M.; Mosse, B. An evaluation of techniques for measuring vesicular arbuscular mycorrhizal infection in roots. New Phytol. 1980, 84, 489–500. [Google Scholar] [CrossRef]
- Di Martino, C.; Delfine, S.; Pizzuto, R.; Loreto, F.; Fuggi, A. Free amino acids and glycine betaine in leaf osmoregulation of spinach responding to increasing salt stress. New Phytol. 2003, 158, 455–463. [Google Scholar] [CrossRef]
- Lowry, O.H.; Rosebrough, N.J.; Farr, A.L.; Randall, R.J. Protein measurement with the Folin phenol reagent. J. Biol. Chem. 1951, 193, 265–275. [Google Scholar] [CrossRef]
- Gibon, Y.; Blaesing, O.E.; Hannemann, J.; Carillo, P.; Höhne, M.; Hendriks, J.H.M.; Palacios, N.; Cross, J.; Selbig, J.; Stitt, M. A robot-based platform to measure multiple enzyme activities in Arabidopsis using a set of cycling assays: Comparison of changes of enzyme activities and transcript levels during diurnal cycles and prolonged darkness. Plant Cell 2004, 16, 3304–3325. [Google Scholar] [CrossRef]
- Bordallo, J.J.; Lopez-Llorca, L.V.; Jansson, H.B.; Salinas, J.; Persmark, L.; Asensio, L. Colonization of plant roots by egg-parasitic and nematode-trapping fungi. New Phytol. 2002, 154, 491–499. [Google Scholar] [CrossRef]
- NCBI. Resource Coordinators Database Resources of the National Center for Biotechnology Information. Nucleic Acids Res. 2018, 46, D8–D13. [Google Scholar] [CrossRef]
- Benson, D.A.; Cavanaugh, M.; Clark, K.; Karsch-Mizrachi, I.; Lipman, D.J.; Ostell, J.; Sayers, E.W. GenBank. Nucleic Acids Res. 2013, 41, D36–D42. [Google Scholar] [CrossRef]

| Microorganisms in Roots | Gene Bank Code | % Frequency Site A | % Frequency Site B | ||
|---|---|---|---|---|---|
| NM | M | NM | M | ||
| Fusarium avenaceum | OM417228 | 90% | 55% | 85% | 40% |
| Fusarium algeriense | OM417243 | 20% | 30% | 40% | 20% |
| Alternaria alternata * | OM422688 | 30% | 50% | - | - |
| Alternaria alternata ** | OM422689 | - | - | 35% | 50% |
| Alternaria infectoria | OM422690 | 25% | 55% | 30% | 45% |
| Alternaria tellustris | OM422702 | 20% | 30% | 20% | 30% |
| Cladorrhinum australe | OM422711 | 65% | 30% | 30% | 30% |
| Macrophomina phaseolina | OM422725 | 75% | 30% | 50% | 40% |
| Fusarium equiseti | OM422743 | 70% | 40% | 50% | 35% |
| Fusarium chlamydosporum◊ | OM422742 | - | - | 35% | 20% |
| Fusarium chlamydosporum◊◊ | OM429358 | 15% | - | - | - |
| Fusarium chlamydosporum◊◊◊ | OM429359 | 15% | - | - | - |
| Fusarium chlamydosporum◊◊◊◊ | OM429357 | 35% | - | - | - |
| Isolates | Results |
|---|---|
| Fusarium avenaceum | + + |
| Fusarium algeriense | + + |
| Alternaria alternata */** | + + + |
| Alternaria infectoria | + + + |
| Alternaria tellustris | + + |
| Cladorrhinum australe | + |
| Macrophomina phaseolina | – |
| Fusarium equiseti | + + |
| Fusarium chlamydosporum◊/◊◊◊◊ | + + |
| Days Post-Inoculation | % of Inhibition by A. tellustris | |
|---|---|---|
| Fusarium | Rhizoctonia | |
| 4 | 10.5 ± 2.0 | 41.7 ± 1.1 |
| 8 | 54.9 ± 2.7 | 45.2 ± 0.8 |
| Larino (A) | Rotello (B) | ||
|---|---|---|---|
| coarse sand | 18% ± 3% | coarse sand | 11% ± 2% |
| fine sand | 24% ± 4% | fine sand | 36% ± 6% |
| silt | 32% ± 6% | silt | 13% ± 3% |
| clay | 38% ± 7% | clay | 40% ± 7% |
| pH | 7.36 ± 0.2 | pH | 7.4 ± 0.1 |
| CaCO3 total | 9% ± 1.5% | CaCO3 total | 9% ± 1.8% |
| CEC | 18 cmol (+) kg−1 ± 2 | CEC | 19 cmol (+) kg−1 ± 2 |
| total organic carbon | 8.4 g kg−1 ± 1.5 | total organic carbon | 8.5 g kg−1 ± 1.5 |
| total Nitrogen | 1.1 g kg−1 ± 0.2 | total nitrogen | 1.2 g kg−1 ± 0.2 |
| P2O5 | 19.2 mg kg−1 ± 3 | P2O5 | 19.7 mg kg−1 ± 3 |
| C/N | 7.6 ± 1.5 | C/N | 7.1 ± 1.4 |
| Treatment | Date | Phenological Stage | A (NM) | A (M) | B (NM) | B (M) |
|---|---|---|---|---|---|---|
| Basic fertilization | 2019/10/10 | - | 100 kg/ha−1 | - | 100 kg/ha−1 | - |
| 2nd fertilization | 2020/02/04 | Tillering | 90 kg/ha−1 | 45 kg/ha−1 | 90 kg/ha−1 | 45 kg/ha−1 |
| 2nd fertilization | 2020/02/18 | Tillering | 90 kg/ha−1 | 45 kg/ha−1 | 90 kg/ha−1 | 45 kg/ha−1 |
| 3rd fertilization | 2020/03/14 | Stem extension | 100 kg/ha−1 | 50 kg/ha−1 | 100 kg/ha−1 | 50 kg/ha−1 |
| 3rd fertilization | 2020/03/26 | Stem extension | 100 kg/ha−1 | 50 kg/ha−1 | 100 kg/ha−1 | 50 kg/ha−1 |
Publisher’s Note: MDPI stays neutral with regard to jurisdictional claims in published maps and institutional affiliations. |
© 2022 by the authors. Licensee MDPI, Basel, Switzerland. This article is an open access article distributed under the terms and conditions of the Creative Commons Attribution (CC BY) license (https://creativecommons.org/licenses/by/4.0/).
Share and Cite
Di Martino, C.; Torino, V.; Minotti, P.; Pietrantonio, L.; Del Grosso, C.; Palmieri, D.; Palumbo, G.; Crawford, T.W., Jr.; Carfagna, S. Mycorrhized Wheat Plants and Nitrogen Assimilation in Coexistence and Antagonism with Spontaneous Colonization of Pathogenic and Saprophytic Fungi in a Soil of Low Fertility. Plants 2022, 11, 924. https://doi.org/10.3390/plants11070924
Di Martino C, Torino V, Minotti P, Pietrantonio L, Del Grosso C, Palmieri D, Palumbo G, Crawford TW Jr., Carfagna S. Mycorrhized Wheat Plants and Nitrogen Assimilation in Coexistence and Antagonism with Spontaneous Colonization of Pathogenic and Saprophytic Fungi in a Soil of Low Fertility. Plants. 2022; 11(7):924. https://doi.org/10.3390/plants11070924
Chicago/Turabian StyleDi Martino, Catello, Valentina Torino, Pasqualino Minotti, Laura Pietrantonio, Carmine Del Grosso, Davide Palmieri, Giuseppe Palumbo, Thomas W. Crawford, Jr., and Simona Carfagna. 2022. "Mycorrhized Wheat Plants and Nitrogen Assimilation in Coexistence and Antagonism with Spontaneous Colonization of Pathogenic and Saprophytic Fungi in a Soil of Low Fertility" Plants 11, no. 7: 924. https://doi.org/10.3390/plants11070924
APA StyleDi Martino, C., Torino, V., Minotti, P., Pietrantonio, L., Del Grosso, C., Palmieri, D., Palumbo, G., Crawford, T. W., Jr., & Carfagna, S. (2022). Mycorrhized Wheat Plants and Nitrogen Assimilation in Coexistence and Antagonism with Spontaneous Colonization of Pathogenic and Saprophytic Fungi in a Soil of Low Fertility. Plants, 11(7), 924. https://doi.org/10.3390/plants11070924

